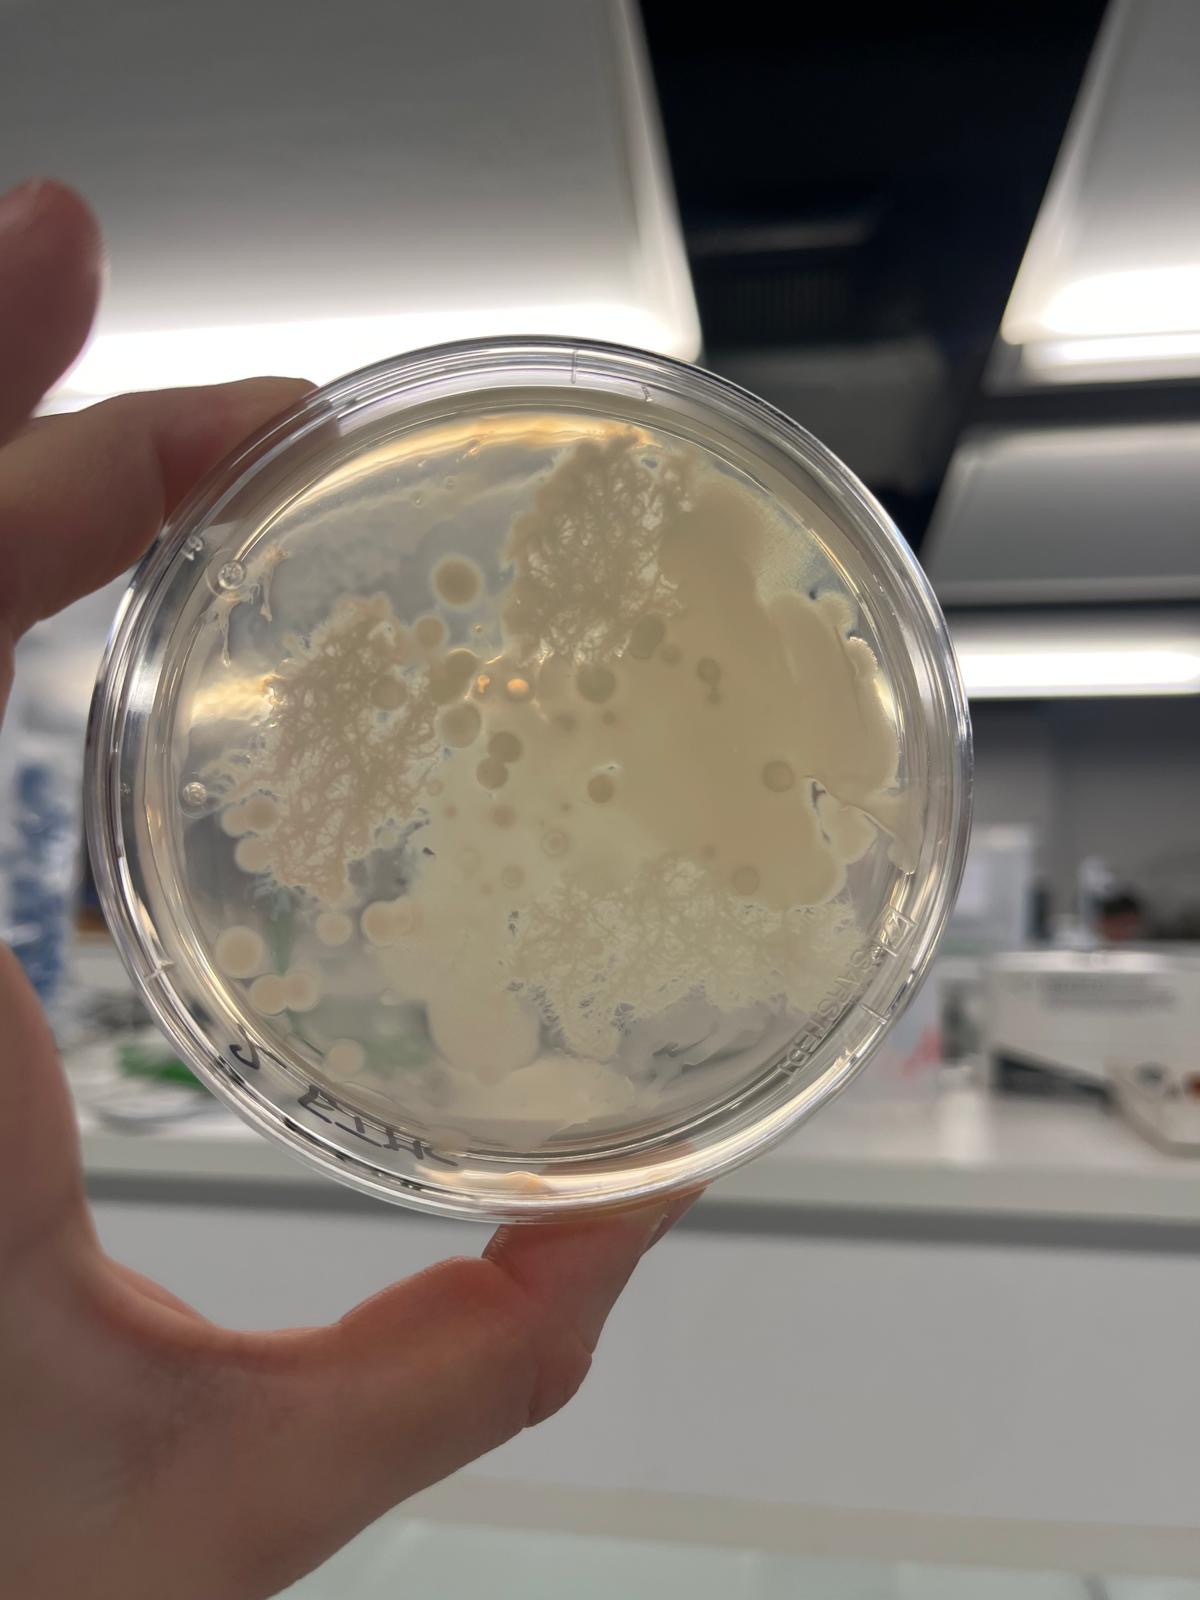
2ad4de5a-e0e5-4c25-9dc4-5db916a45cdf.JPG
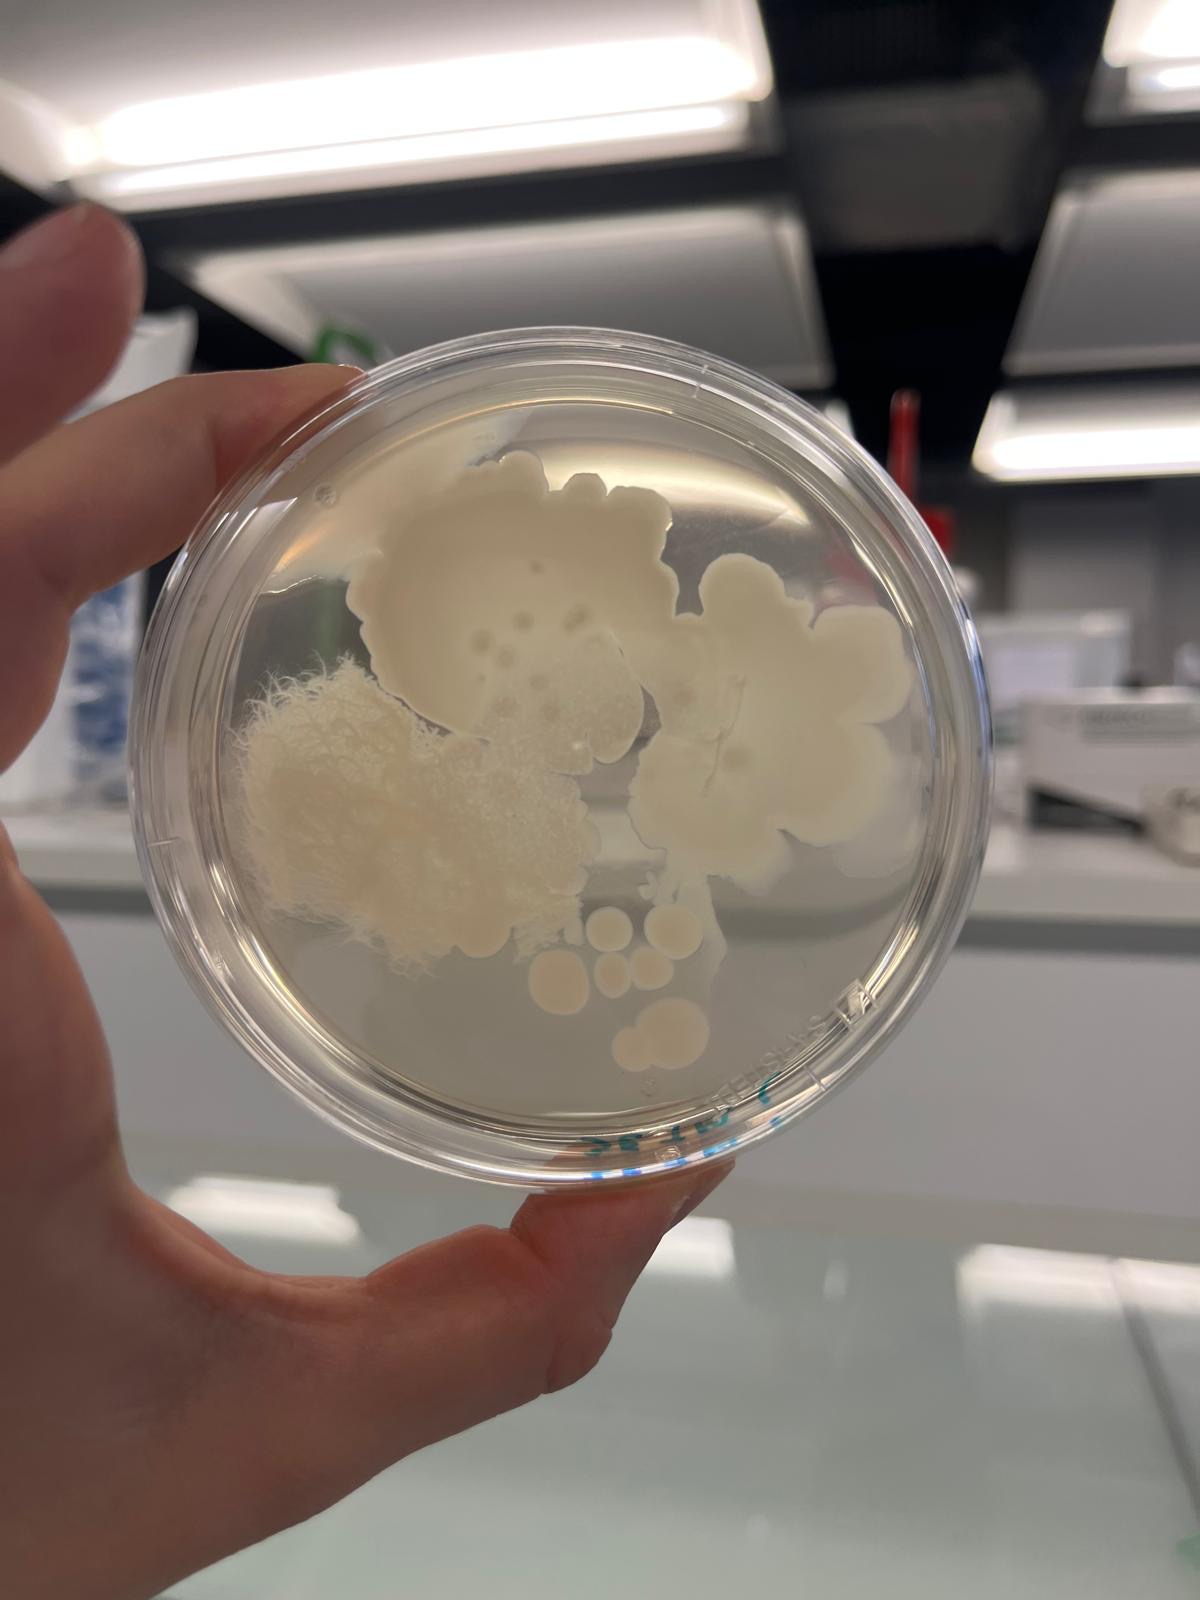
415a1da6-c786-4ead-99a5-a03f5f0d607d.JPG
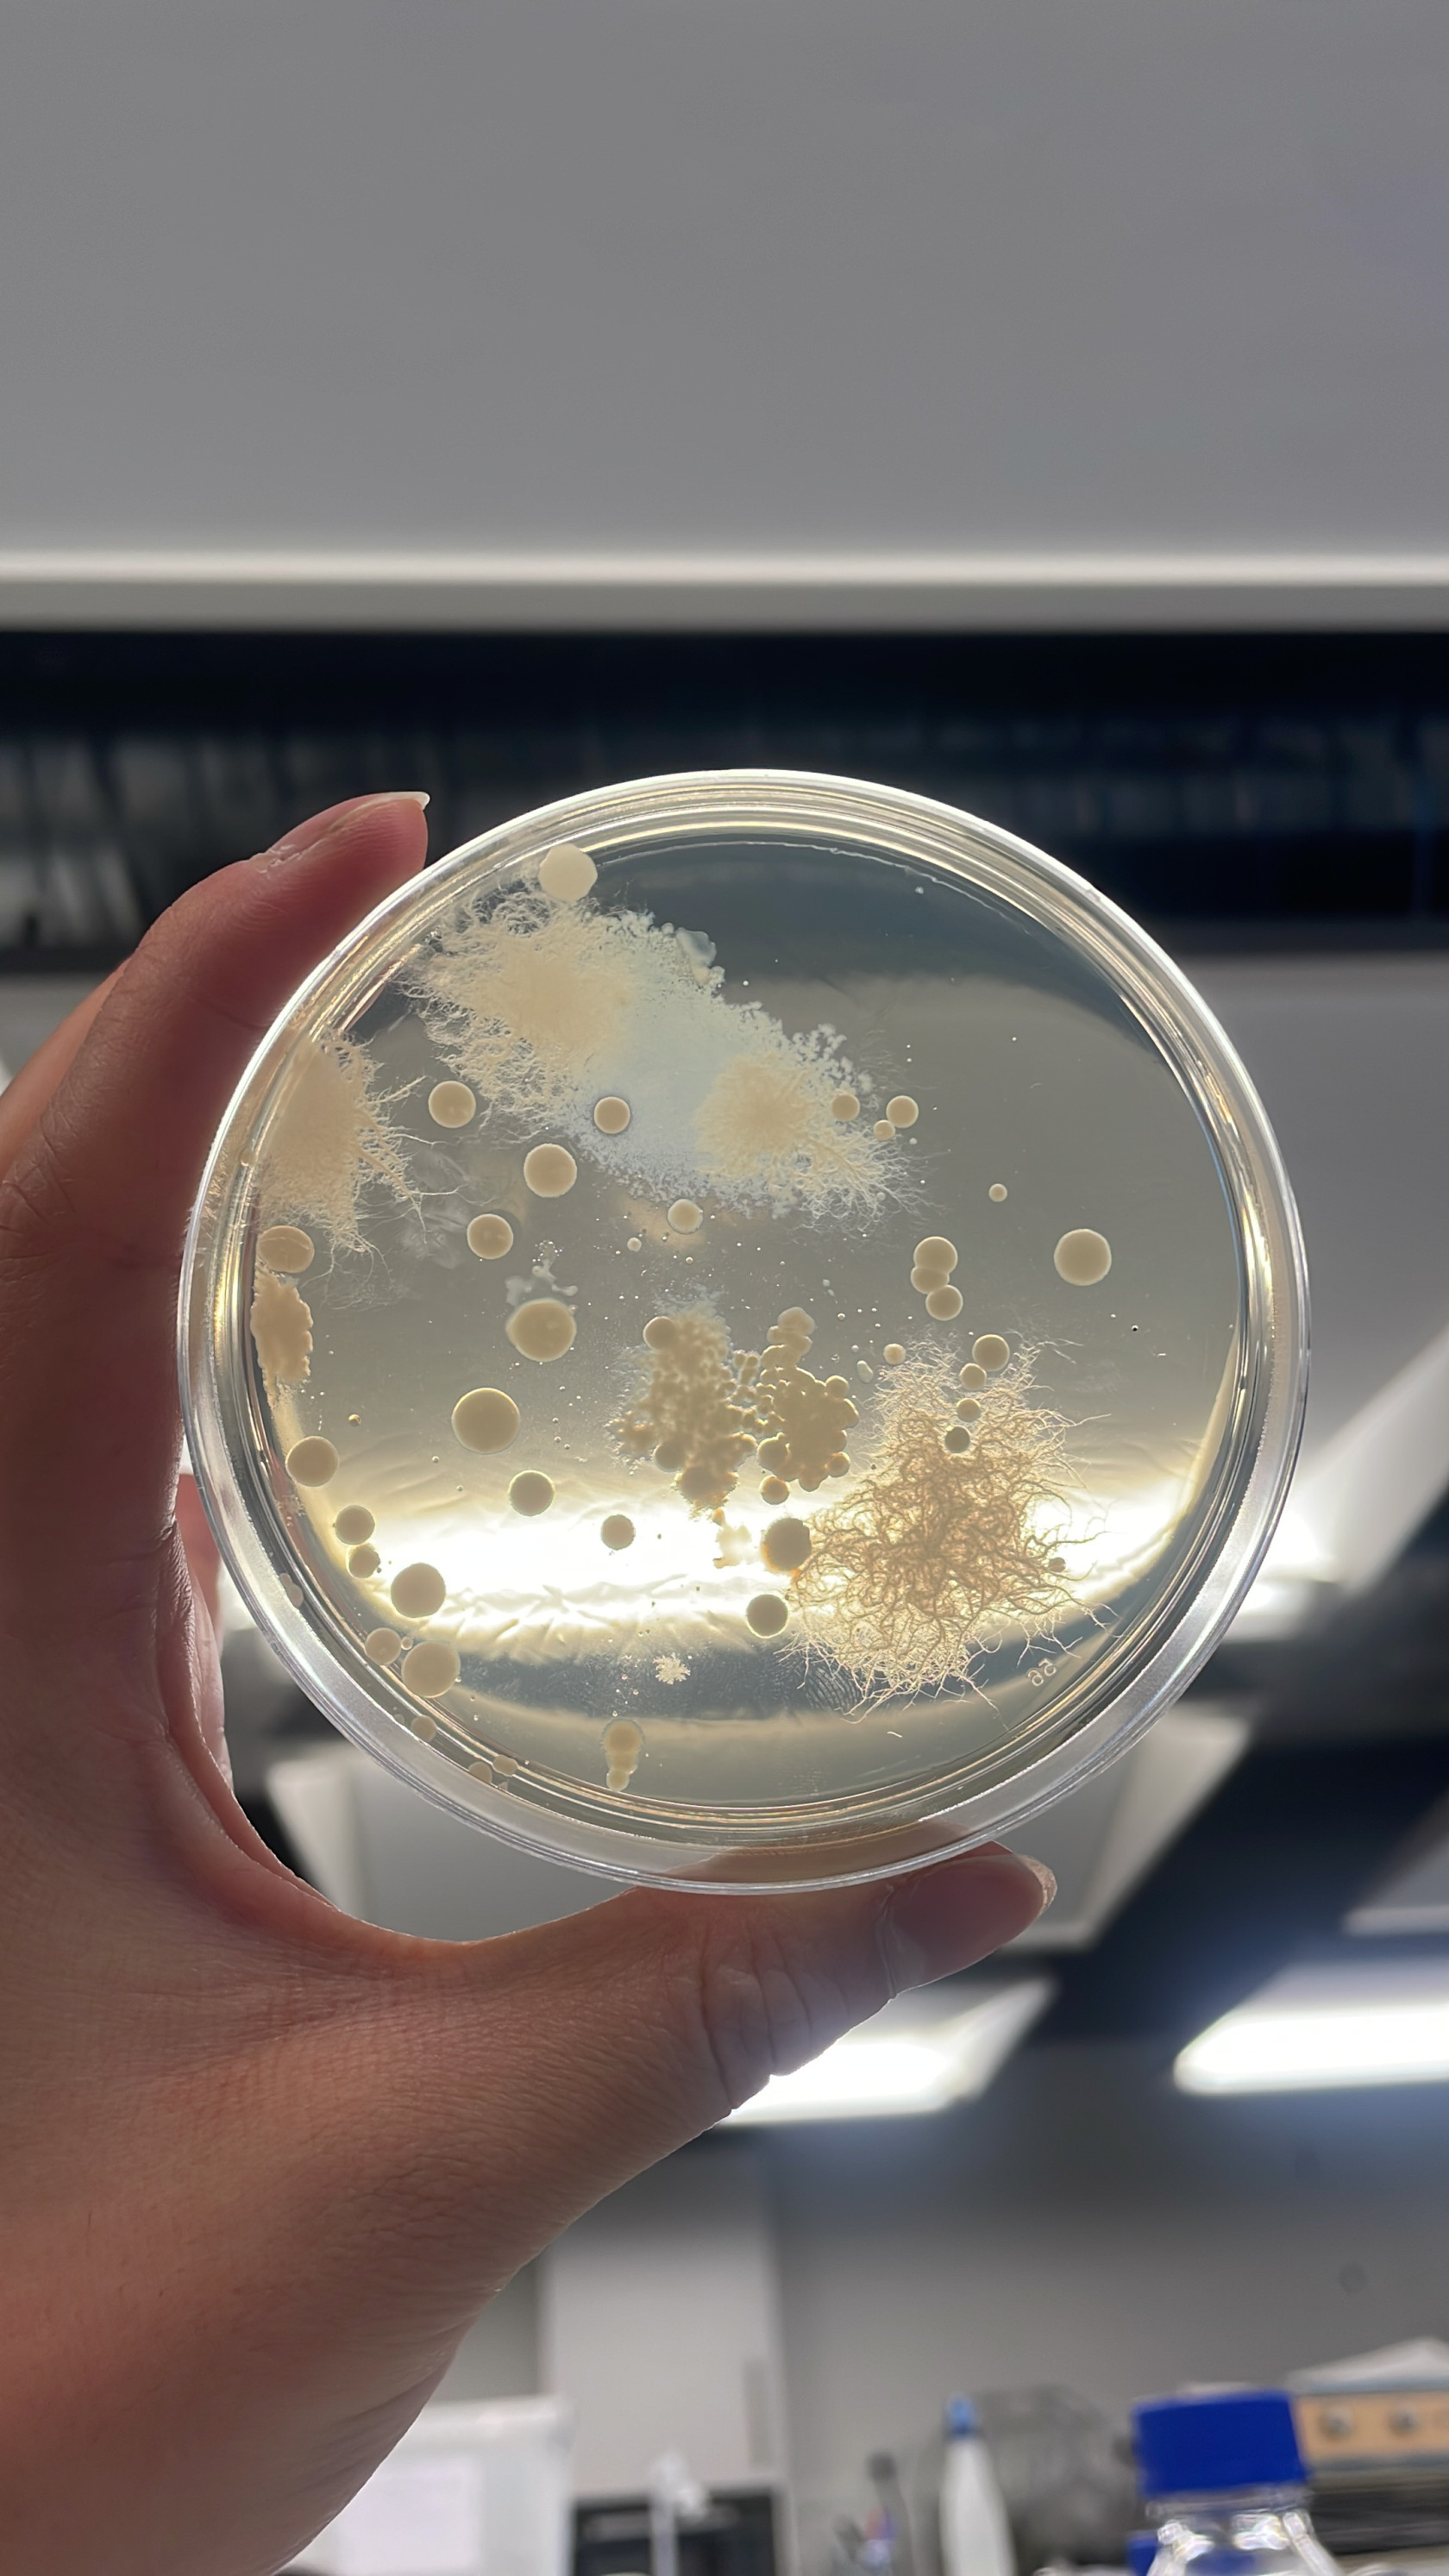
E2304F3F-8C85-455E-976B-40A5EA039231.JPG
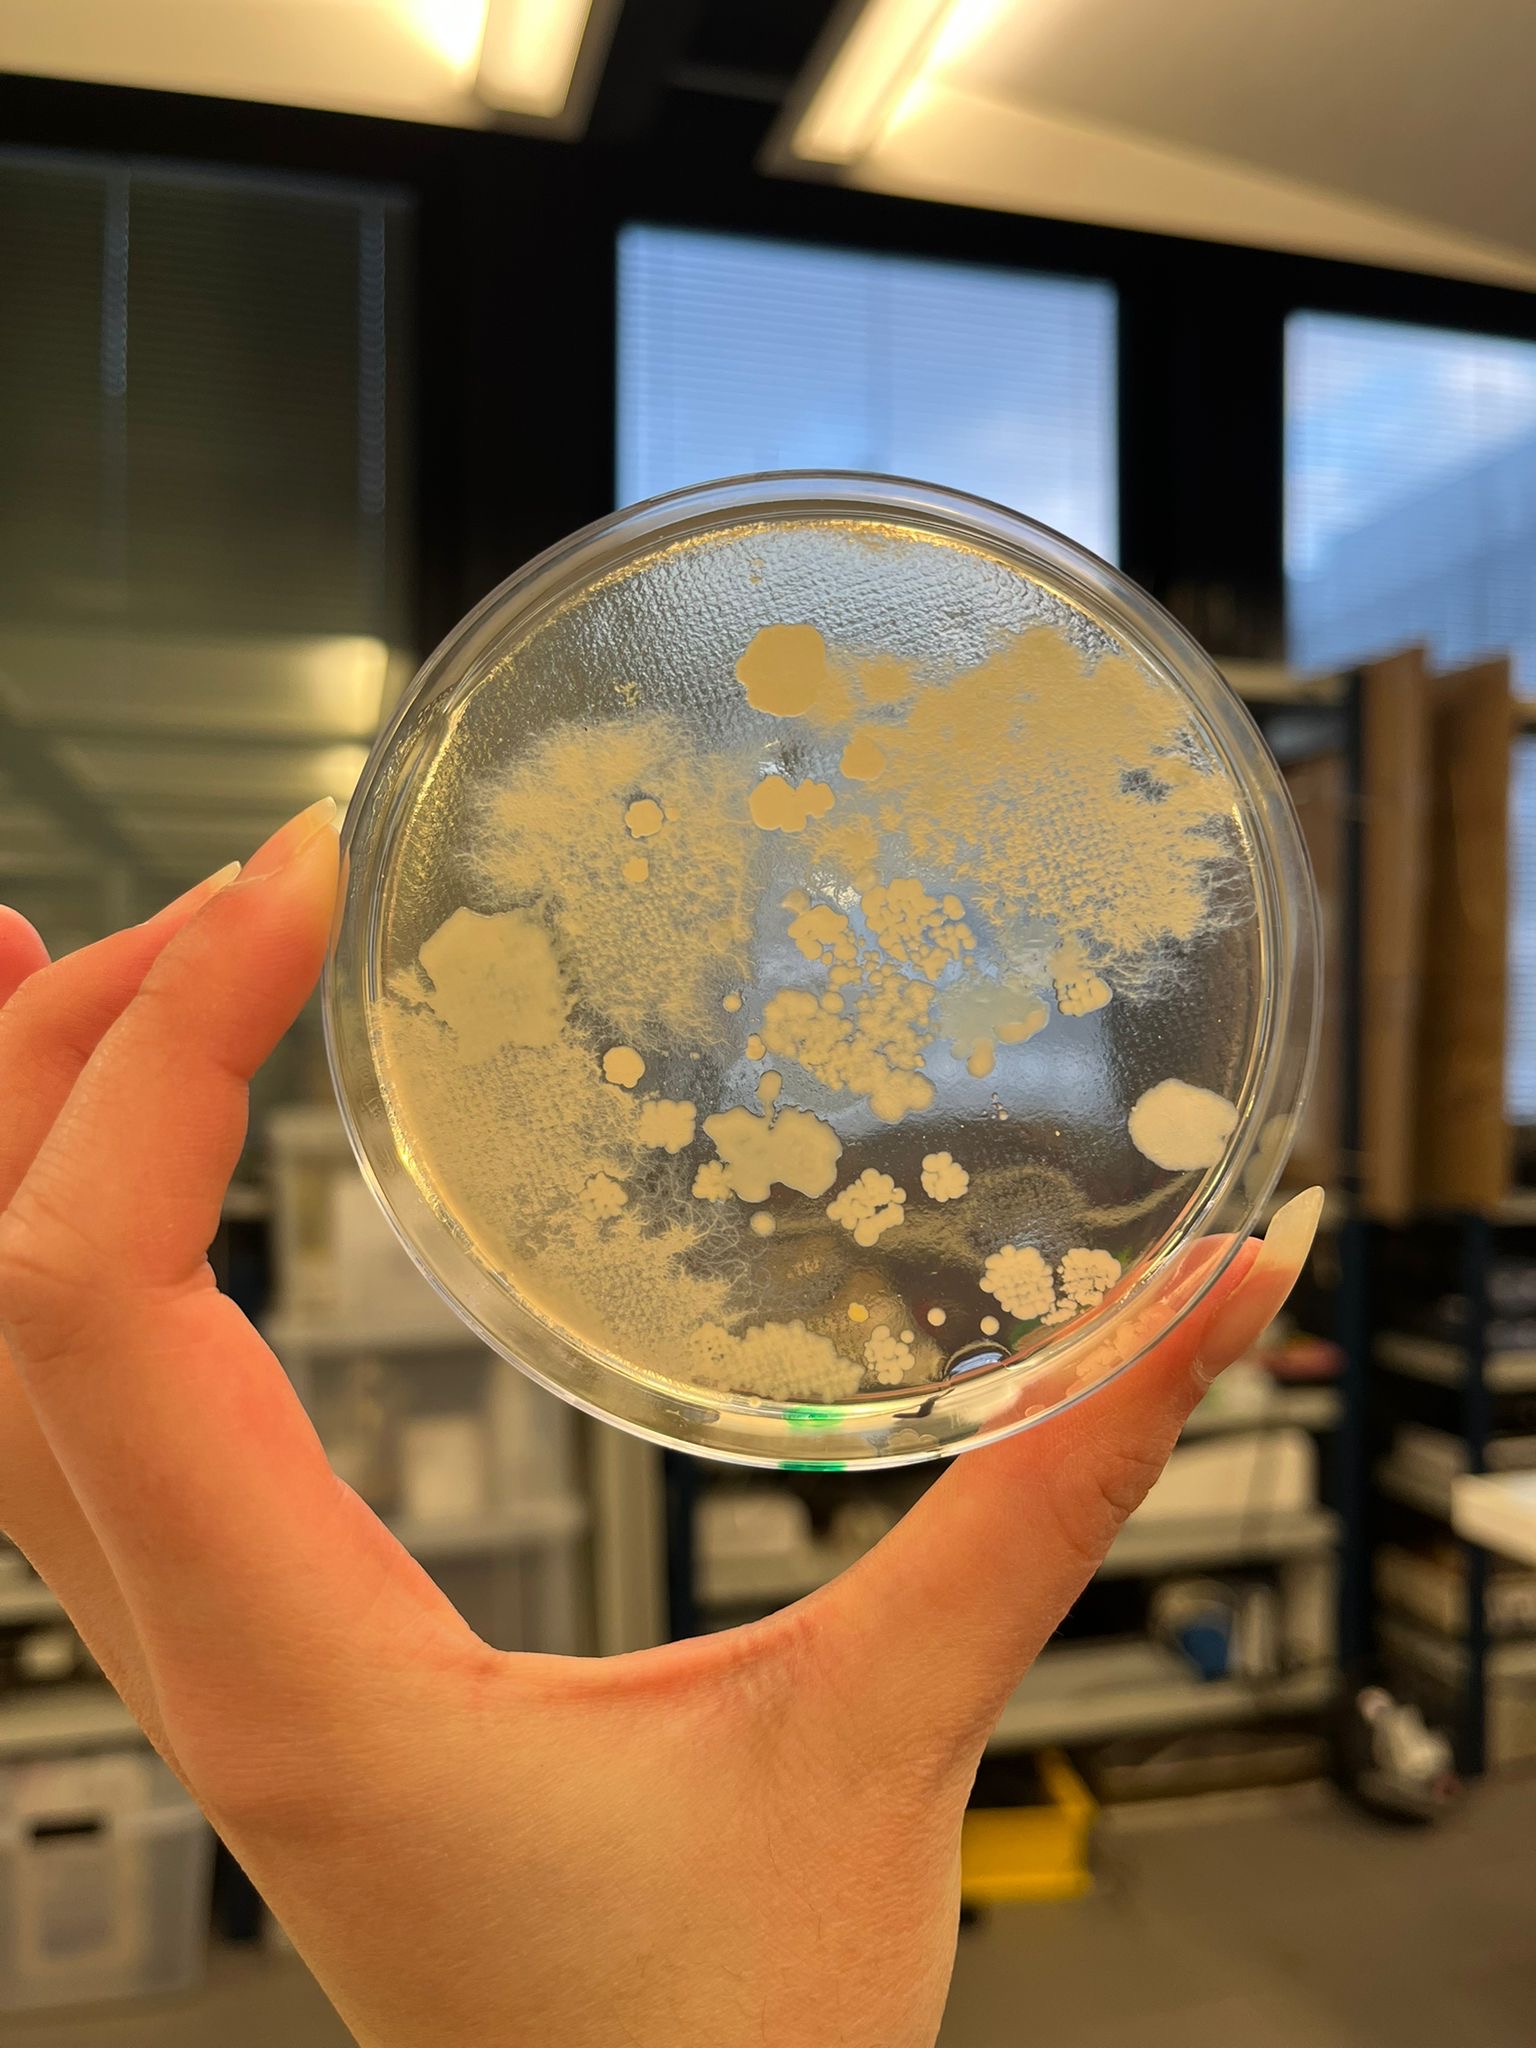
44a18ee5-0d2d-4109-89f0-6037ce0f1bc0.JPG
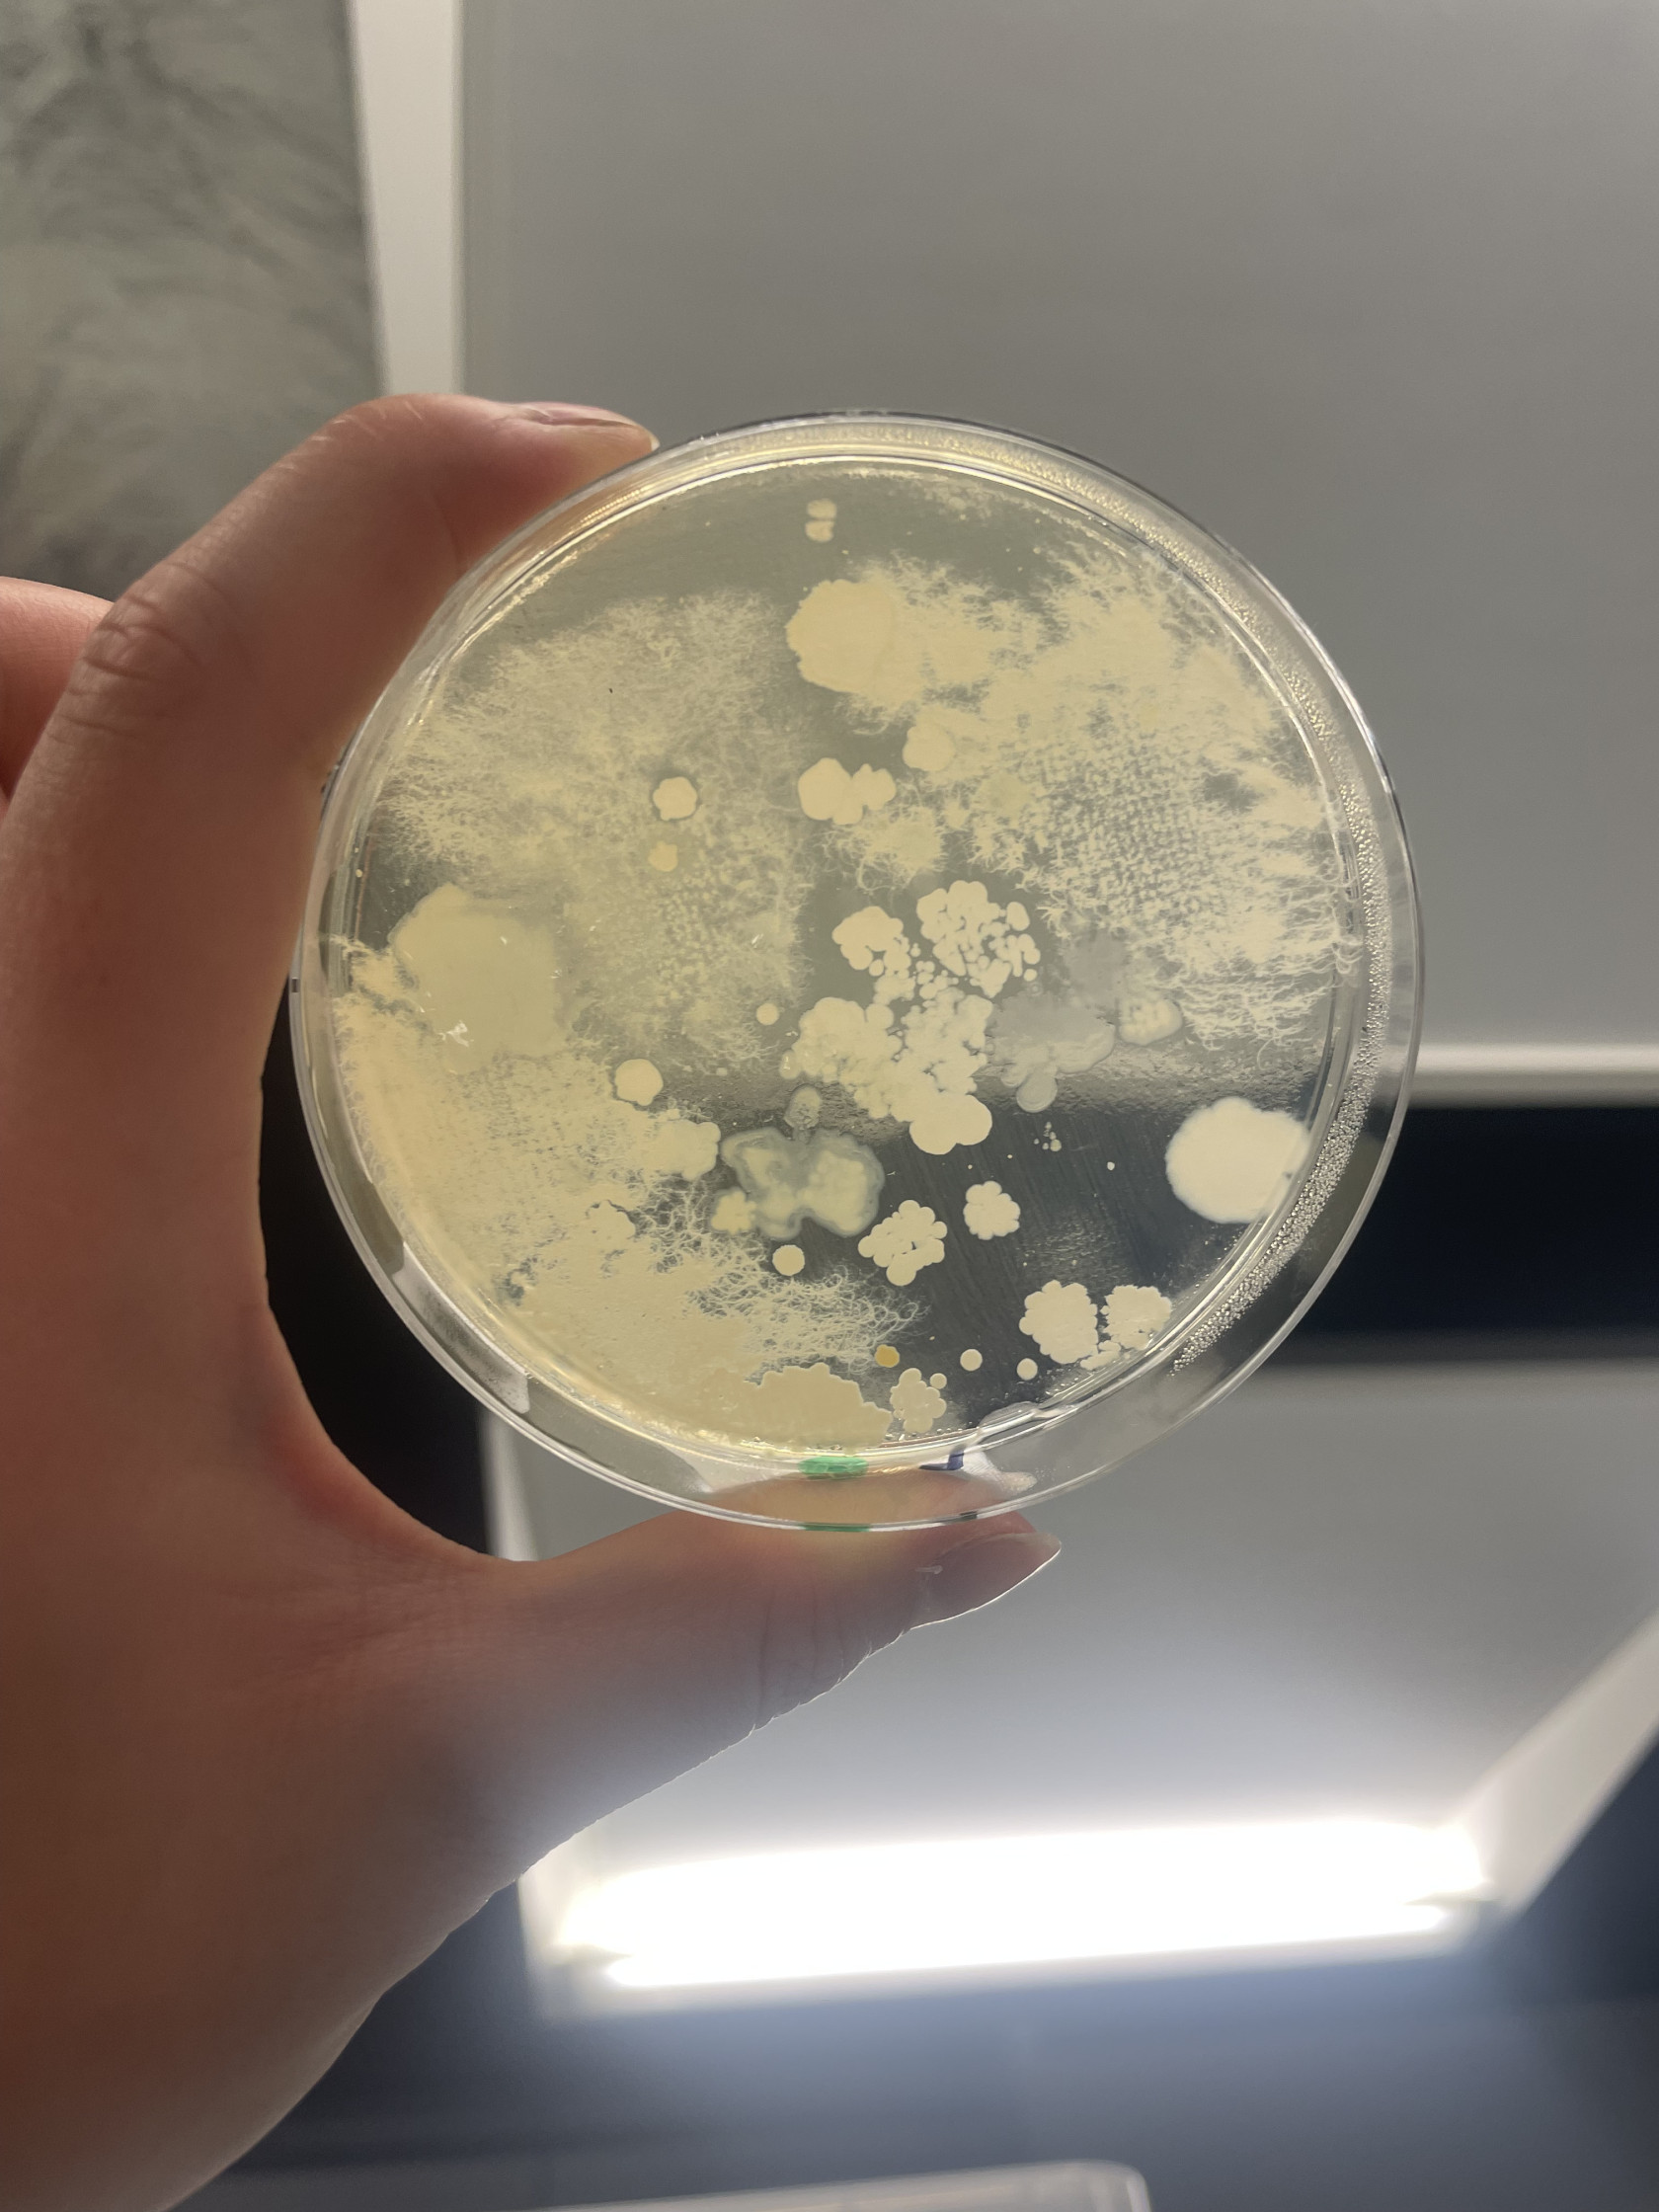
IMG_9272.jpg

LU3SV564 : Impact des pluies acides sur la population des bactéries du sol
INFORMATIONS
- Hutan Thomas: thomashutan@gmail.com
- Emma Husson: emmahusson94@gmail.com
- Melody Schmitt: lpsmelody@yahoo.fr
- Clara Xiang: clara.ixe@hotmail.com
Problématique: Comment le pH des pluies urbaines influencent-ils la diversité, l'aspect et la croissance du bactérie du sol?
Séance 1: 05/11/2025
Objectif de la séance: Tester différent facteur de dilution
Liste du matériel :
-Pelle stérile
-Contenants stériles
-Échantillon de terre
-15g d'Agar-Agar
-20g de LB
-2L d'eau distillé
-9g de NaCl
-Tube de 50mL
-Micropipette
-20 Boites de pétries stériles
Ce qu'on a fait:
-Prélèvement d'échantillon de sol sur 3 zones différentes du site de Jussieu
-Préparation du milieu LB: 15g d'Agar-Agar + 20g de LB pour 1L d'eau distillé
-Préparation de l'eau physiologique: 9g de NaCl + 1L d'eau distillé
-On a pesé 1g de nos échantillons de sol mélangé et on l'a diluer dans 10mL d'eau physiologique, on l'appelle sol 1
-On a fait plusieurs dilution avec la sol 1:
- dilution 1: 200µL de sol 1 + 25mL d'eau physiologique
- dilution 2: 200µL de sol 1 + 50mL d'eau physiologique
- dilution 3: 133µL de sol 1 + 50mL d'eau physiologique
- dilution 4: 100µL de sol 1 + 50mL d'eau physiologique
-On a étaler 20mL de notre milieu LB dans 20 boites de pétrie stérile
-On a étaler 100µL dans 5 boites de pétrie pour chaque facteur de dilution
-On a incubé a 30°C pendant 48h
Séance 2: 07/11/2025
Objectif de la séance: Choix du facteur de dilution et acidification du milieu
Liste du matériel :
-pH mètre
-Solution tampon à pH 4
-Acide chlorhydrique avec gant et lunette de protection
-Pipette pasteur
-15 Boites de pétries stériles
Ce qu'on a fait:
-Refusion du milieu LB
-On a tamponné les pH mètre à l'aide de la solution tampon pH 4
-On a mesuré d'abord le pH du milieu LB puis on a acidifié à l'aide de l'acide chlorhydrique jusqu'à atteindre un pH à 5,6
-On l'a coulé dans 5 boites de pétries stériles.
-On a répété ce processus pour un pH à 4 et à 3
Choix du facteur de dilution:
- dilution 1:
- dilution 2:
- dilution 3:
- dilution 4:
La dilution 2 a été sélectionné car plus comptable et observable(même si la dilution 1 semble plus clair mais c'est due à un milieu LB mal préparé.
Séance 3: 13/11/2025
Objectif de la séance: Préparation de nouvelle boite de pétrie avec le facteur de dilution numéro 2
Liste du matériel :
-Échantillon de terre
-Eau physiologique préparée à la séance 1
-Milieu LB préparée à la séance 1
-6 Boites de pétrie stériles
Ce qu'on a fait:
-Refusion du milieu LB
-On a pesé 1g de nos échantillons de sol mélangé et on l'a diluer dans 10mL d'eau physiologique
-On a fait une dilution avec 200µL de sol 1 + 50mL d'eau physiologique
-On a étaler 20mL de notre milieu LB dans 6 boites de pétrie stériles
-On a étaler 100µL chaque boite de pétrie
-On a incubé a 30°C pendant 24h
Séance 4: 14/11/2025
Objectif de la séance: Tamponner nos milieux acidifié
On a sélectionné cette boite de pétrie car c'est la plus exploitable:
Liste du matériel :
-Tampon
Ce qu'on a fait:
-On a tamponné nos milieux acidifié
-On les a mis au froid pendant 4 jours car week-end entre temps
Séance 5: 19/11/2025
Objectif de la séance: Observation des milieux
Ce qu'on a fait:
-On a sorti les boites du froid pour les laisser a température ambiante
Observation:
Très peu de bactéries sur nos boites a pH 5,6 et inexistante sur nos boites de pétrie a pH 4 et 3. Cela peut sans doute être du à une longue exposition au froid.
Séance 6: 21/11/2025
Objectif de la séance: Préparation d'un nouveau milieu LB
Liste du matériel :
-7,5g d'Agar-Agar
-10g de LB
-500mL d'eau distillé
Ce qu'on a fait:
-Préparation du milieu LB: 7,5g d'Agar-Agar + 10g de LB pour 500mL d'eau distillé
Séance 7: 24/11/2025
Objectif de la séance: Répétition de nos expériences
Liste du matériel :
-Échantillon de terre
-Eau physiologique préparée à la séance 1
-Milieu LB préparée à la séance 1
-6 Boites de pétrie stériles
Ce qu'on a fait:
-Refusion du milieu LB
-On a pesé 1g de nos échantillons de sol mélangé et on l'a diluer dans 10mL d'eau physiologique
-On a fait une dilution avec 200µL de sol 1 + 50mL d'eau physiologique
-On a étaler 20mL de notre milieu LB dans 6 boites de pétrie stériles
-On a étaler 100µL chaque boite de pétrie
-On a incubé à 30°C pendant 24h
Séance 8: 25/11/2025
Objectif de la séance: Répétition de nos expériences
Liste du matériel :
-pH mètre
-Solution tampon à pH 4
-Acide chlorhydrique avec gant et lunette de protection
-Pipette pasteur
-15 Boites de pétries stériles
-Tampon
Ce qu'on a fait:
-Refusion du milieu LB
-On a tamponné les pH mètre à l'aide de la solution tampon pH 4
-On a mesuré d'abord le pH du milieu LB puis on a acidifié à l'aide de l'acide chlorhydrique jusqu'à atteindre un pH à 5,6
-On l'a coulé dans 5 boites de pétries stériles.
-On a répété ce processus pour un pH à 4 et à 3
-Après gélification de nos milieux, on a tamponné à partir d'une boite de pétrie issue de la séance 7 qui selon nous est la plus exploitable:
-On les a incubé à 30°C pendant 24h
Séance 9: 26/11/2025
Objectif de la séance: Répétition de nos expériences
Observation de nos boites de pétries:
pH 5,6:
pH 4:
pH 3:
On observe que sur nos milieux acidifiés à pH 5,6 il y a des bactéries qui s'y sont développées tandis que sur nos milieux à pH 4 et 3, il n'y a aucune bactérie visible
Séance 10: 27/11/2025
Objectif de la séance: Répétition de nos expériences
Observation de nos boites de pétries:
pH 5,6:
pH 4:
pH 3:
On observe que sur nos milieux acidifiés à pH 4 il y a de petites colonies individuelles de bactéries qui s'y sont développées tandis que sur nos milieux à pH 3, il y a toujours aucune bactérie visible.
Séance 11: 28/11/2025
Objectif de la séance: Répétition de nos expériences
Observation de nos boites de pétries:
pH 5,6:
pH 4:
pH 3:
On observe que sur nos milieux acidifiés à pH 4, les petites colonies individuelles de bactéries observés à la séance 10 ont augmenté de volume(on va alors chercher à mesurer l'évolution de la surface de ces colonies durant ces 3 jours) tandis que sur nos milieux à pH 3, il y a toujours aucune bactérie visible.
Liste de matériel:
-Iode, fuschine, éthanol et cristal violet
Ce qu'on a fait:
-Coloration de GRAM
Observation:
Bactéries issues d'une milieu à pH 5,6:
Bactéries issues d'une milieu à pH 4:
Séance 12: 05/12/2025
Objectif de la séance: Analyse des résultats
On a utilisé Mesurim2 pour mesurer la surface de nos colonies de bactéries et utilisé R pour tracer quelque graphe. Nous pensons plutôt à utiliser Python.
Rapport de TP:
LU3SV564 06/12/2025
L’effet de l’acidité des pluies sur les bactéries du sol
de Emma HUSSON, Thomas HUTAN, Melody SCHMITT et Clara XIANG
INTRODUCTION
En écologie urbaine, la ville est considérée comme un véritable écosystème où les interactions entre les êtres vivants et leur environnement sont profondément influencées par les activités anthropiques.
Nous nous sommes intéressés au sol urbain qui correspond à la fine couche superficielle de la croûte terrestre issue de l’altération de la roche-mère et de l’accumulation de matière organique [1]. Le sol abrite une grande diversité d’organismes ; la macrofaune (lombrics, myriapodes…) de taille supérieure à 2 mm, la mésofaune (acariens, collemboles…) de taille intermédiaire et la microfaune (nématodes, champignons, bactéries…) de taille inférieure à 0,2 mm. Ils participent à la dynamique du sol et sont responsables de la décomposition et minéralisation de la matière organique ou encore de la bioturbation améliorant l’aération, la porosité et l’infiltration de l’eau. D’après la FAO (Food and Agriculture Organization), un gramme de sol peut contenir jusqu’à 10⁹ cellules bactériennes, appartenant à plusieurs milliers d’espèces différentes [2].
Or, depuis la révolution industrielle, l'eau de pluie en milieu urbain présente une légère acidité ce qui pourrait avoir une influence sur la microfaune du sol.
En effet, en conditions naturelles, l'eau présente un pH d'environ 5,6. Or, en ville, celui-ci peut diminuer en raison de la présence de polluants atmosphériques tels que les oxydes de soufre (SO₂) et d'azote (NOₓ), principalement issus de la combustion de carburants fossiles, qui réagissent dans l’atmosphère avec l’eau ou l’oxygène pour former des acides sulfurique (H₂SO₄) et nitrique (HNO₃) [3].
Ainsi, en Europe et particulièrement en France, au moins 20% des espèces végétales et animales ont disparu dans les lacs touchés par des dépôts acides [5]. De nombreuses politiques et lois ont alors été mises en place afin de réduire significativement les émissions de SO₂ de 84% et de NOₓ de 53% au sein de l’UE entre 2005 et 2023. Cela a entraîné une amélioration générale de la qualité des précipitations [6]. Cependant, en région parisienne, les concentrations en oxydes d’azote demeurent élevées dans les zones à fort trafic. En effet, la qualité de l’air varie selon les zones : elle est généralement meilleure dans les espaces verts, tandis qu’elle se dégrade à proximité des grands axes routiers et des zones industrielles. Cette hétérogénéité accentue localement l’acidité des précipitations affectant les écosystèmes urbains [7].
C’est pourquoi notre étude porte sur l’acidité des pluies et sur son impact sur la microfaune du sol. Comment le pH des pluies urbaines influence-t-il la diversité, l’aspect et la croissance des bactéries du sol?
Pour y répondre, dans un premier temps, nous avons prélevé des échantillons de sol urbain dans le but d’y retrouver la microfaune typique des sols. Ensuite, par simulation de pluies acides par baisse de pH, nous avons étudié l’impact de ces eaux acides sur notre microfaune selon la croissance des bactéries, la diversité et l’aspect de nos colonies.
Notre hypothèse est que la diminution du pH des pluies entraîne une réduction de la diversité bactérienne, voire une sélection de certaines bactéries et ralentit la croissance des colonies dans les sols urbains de Paris ; certaines espèces étant plus sensibles à l’acidité que d’autres.
En effet, des études métagénomiques et d’analyses 16S réalisées sur des sols urbains montrent une dominance des phyla Proteobacteria, Actinobacteria, Acidobacteria, Firmicutes et Bacteroidetes [8]. D’après nos prédictions expérimentales, sur nos milieux LB contrôle (pH à 5,6), nous prévoyons donc d’observer principalement les genres typiques des sols urbains : Bacillus (colonies sèches et opaques) [9], Pseudomonas (colonies lisses et pigmentées) [10], Streptomyces (colonies poudreuses et filamenteuses) [11], Micrococcus (petites colonies jaunes) [12] et, plus rarement, des Enterobacter en cas de contamination organique. Lorsque le pH sera abaissé à 4,0, nous prévoyons une diminution de la diversité et du nombre de colonies. Les bactéries sporulantes comme Bacillus et les cocci résistants tels que Micrococcus devraient subsister [13], tandis que Pseudomonas et Streptomyces présenteraient des croissances ralenties. Enfin, à forte acidification (pH 3,0), seules quelques colonies de Bacillus devraient être observées, la majorité des autres genres étant incapables de se développer dans ces conditions extrêmes [14].
I- Matériels et méthodes
-
Réalisation de la gamme de dilutions et sélection de la dilution optimale
Le but ici est de choisir le facteur de dilution optimal en diluant progressivement l’échantillon du sol jusqu’à obtenir des colonies bactériennes suffisamment isolées sur boîte de Petri pour être observées et comptées.
- Échantillon du sol - Eau physiologique
- Balance de précision - Micropipette
- 5 tubes Falcon de 50 mL - 25 boîtes de Petri
1- Prélever du sol dans 3 différentes zones du site de Jussieu et mélanger
2- Transférer 1g de l’échantillon du sol dans un tube Falcon contenant 10 mL d’eau physiologique
3- Transférer 200 µL de la solution dans un tube Falcon contenant 25, 50, 75 ou 100 mL d’eau physiologique correspondant aux différents facteurs de dilution
4- Vortexer chaque dilution pour homogénéiser
5- Etaler 100 µL de chaque dilution sur 5 boîtes de Pétri contenant le milieu LB (25 boîtes en tout)
6- Incuber 24 à 48h dans une étuve à 30°C
7- Observer et choisir le facteur de dilution présentant des colonies isolées et observables
A l'issue de cette expérience, nous avons choisi la dilution correspondant au tube contenant 50 mL d’eau physiologique, soit un facteur de dilution de 250.
-
Mise en culture des bactéries sur milieux LB acidifiés (préparation et ensemencement)
Le but est d’étudier l'influence du pH sur la diversité, l’aspect et la croissance des bactéries du sol.
- Agar-agar - Gants et lunette de protection
- LB - pH-mètre
- Eau distillée - 15 boîtes de Petri
- Acide chlorhydrique - Tampon réplicateur pour boîte de Petri
1- Préparer le milieu LB en mélangeant 15g d’Agar-Agar et 20g de LB pour 1L d’eau distillée puis le chauffer
2- Acidifier le milieu LB avec de l’HCl jusqu’à atteindre des valeurs de pH de 5,6 ; 4 et 3 mesurées à l’aide d’un pH-mètre
3- Couler 20 mL du milieu LB acidifié à un pH donné dans 5 boîtes de Petri
4- Laisser refroidir
5- Préparer la dilution à un facteur 250 (cf. sous-partie 1)
6- Tamponner la meilleure dilution sur nos 15 boîtes de Petri acidifiées
7- Incuber les boîtes de Petri dans une étuve à 30°C
-
Suivi expérimental et caractérisation des colonies bactériennes
Le but est de suivre et quantifier la croissance des différents types de colonies bactériennes dans le temps et d’identifier les différents genres présents selon le pH.
- Logiciel Mesurim 2
- Coloration de Gram (violet de gentiane, lugol et safranine)
- Microscope optique
- Loupe binoculaire
1- Observer la croissance et l’analyser à l’aide du logiciel Mesurim 2 (mesure de surfaces)
2- Observer à la loupe binoculaire la morphologie des colonies
3- Observer au microscope la coloration de Gram
II- Résultats
-
Influence du pH sur l’abondance relative et la richesse des différents genres de bactéries
|
Aspect |
Gram |
Forme |
Hypothèse de genre |
|---|---|---|---|
|
Blanche, sèche |
+ |
Bacille |
Bacillus |
|
Verte, brillante |
- |
Bacille |
Pseudomonas |
|
Jaune, lisse |
+ |
Cocci |
Micrococcus |
|
Grise, poudreuse |
+ |
Filamenteuse |
Streptomyces |
Tableau 1 : Hypothèse des genres de bactéries selon l’aspect des colonies à l’observation
Sources: [9], [10], [11], [12]


Figure 4 : Graphique de l’abondance relative des différents genres de bactéries selon le pH après 3 jours d’incubation sur boîtes de Petri
|
Boîtes de Petri à pH 5,6 (témoin) |
Boîtes de Petri à pH 4 |
Boîtes de Petri à pH 3 |
|
|
Genres et abondance relative des bactéries observées |
34,31 ± 2,21 % Streptomyces 5,41 ± 0,24 % Bacillus 0,062 ± 0,005 % Micrococcus 14,31 ± 0,40 % Pseudomonas |
4,92 ± 1,13 % Pseudomonas 5,36 ± 1,01 % Bacillus |
aucun genre observé |
|
Richesse |
4 |
2 |
0 |
Tableau 2 : Tableau recensant les caractéristiques des bactéries du sol selon le pH après 3 jours d’incubation sur boîtes de Petri
Suite à des observations à l'œil nu et au microscope (figures 2 et 3), nous avons pu faire des études morphologiques à l’aide des données du tableau 1 et identifier les différentes communautés bactériennes présentes sur nos boîtes de Petri. Nous avons également établi la richesse spécifique qui correspond au nombre de genres de bactéries différents présents dans nos milieux selon le pH et calculer l’abondance relative (tableau 2) selon la formule suivante :
![]()
Sur nos boîtes témoins à pH 5.6, la richesse spécifique est la plus élevée. En effet, on observe 4 genres de bactéries différents. Streptomyces et Pseudomonas sont les deux genres majoritairement présents (à environ respectivement 35% et 14%). Streptomyces est 6 fois significativement plus abondant que Bacillus et près de 550 fois plus que Micrococcus. Pseudomonas est également trois fois plus présent que Bacillus tandis que Micrococcus est le genre minoritaire (0,062%).
Lorsque le pH vaut 4, la richesse spécifique est divisée par deux. Il ne subsiste que Pseudomonas et Bacillus. L’abondance de Pseudomonas est significativement 3 fois moins importante qu’à un pH de 5,6. Néanmoins, à pH 5,6 et 4, il n’y a pas de différence significative sur l’abondance des Bacillus (environ 5%).
Enfin, lorsque le pH vaut 3, l’abondance et la richesse sont nulles; nous n’observons aucune colonie bactérienne.
-
Influence du pH sur la vitesse de croissance des différents genres de bactéries

Figure 5 : Graphique de l’évolution de la surface moyenne colonisée par les bactéries en fonction du temps à pH 5,6
D’après la figure 5, nous pouvons nous intéresser à la vitesse de colonisation des différentes communautés bactériennes grâce aux équations des droites de régression linéaire.
Premièrement, à pH 5.6, la vitesse de colonisation de Streptomyces est de 337 mm²/jour soit près de 6 fois significativement plus élevée que celles des autres colonies. Ensuite, Pseudomonas se développe environ 2 fois plus vite que Bacillus et présente une vitesse de croissance intermédiaire de 54 mm²/jour tandis que Micrococcus possède la plus faible vitesse de développement (2 mm²/jour).

Figure 6 : Graphique de l’évolution de la surface moyenne colonisée par les bactéries en fonction du temps à pH 4
Lorsque le pH vaut 4 (figure 6); nous remarquons que les colonies bactériennes n’apparaissent qu’à partir du deuxième jour après incubation à 30°C ; leur croissance est ralentie par rapport à celle de nos témoins. De plus, leur surface est significativement plus faible que celle de nos témoins.
En ce qui concerne la vitesse de croissance à pH 3, aucune colonie n’est observable, même après 5 jours d’incubation.
III- Discussion
Notre démarche expérimentale cherchait à déterminer l’impact des pluies acides sur les bactéries du sol. D’après nos prédictions, nous nous attendions à observer, à pH 5,6 des Bacillus, Pseudomonas, Streptomyces et Micrococcus ; à pH 4, essentiellement des Bacillus et les cocci résistants tels que Micrococcus ; et à pH 3, seulement quelques bactéries résistantes. Nos résultats montrent que la richesse bactérienne diminue d’un facteur 2 lorsque le pH passe de 5,6 à 4. A pH 3, aucune colonie n’est observée. Ces observations sont cohérentes avec ce qui est décrit dans la littérature, où les pluies acidifiées entraînent une diminution du développement des bactéries [15].
Notre étude comporte néanmoins plusieurs limites. En effet, il y a le temps restreint pour mener nos expériences, le fait de n’avoir travaillé qu’à partir d’un seul site d'échantillonnage ou le matériel pour l’identification précise des genres de bactéries. De plus, dans les conditions naturelles, l’acidité n’est pas l’unique facteur influençant le développement des bactéries du sol. En outre, l’eau peut également accumuler divers polluants ou composés chimiques avant d’infiltrer le sol, ce qui influence à son tour la croissance et la composition des bactéries.
Pour aller plus loin, nous pourrions récolter des échantillons de plusieurs endroits différents en France, avec des méthodes mettant en jeu plus de facteurs capables de polluer les pluies avant de contaminer les sols, et enfin utiliser une spectrométrie de masse comme MALDI-TOF qui nous permettrait d’être plus précis sur nos identifications microbiennes.
REMERCIEMENTS
Nous tenons à remercier le jardinier M. Baloup qui nous a aimablement autorisés à prélever de la terre sur le site de Jussieu, rendant possible la réalisation de notre projet.
Également merci à nos professeurs Mme Vignal, Mme Bernard-Verdier et M. Dubois pour leur encadrement tout au long des séances, ainsi que pour leurs conseils.
Nous remercions enfin l’équipe du Fablab, en particulier Mme Zouhir, M. Hubert et M. Fiot, pour leur accompagnement dans l’élaboration de nos protocoles, leurs conseils expérimentaux et le suivi attentif de nos manipulations.
BIBLIOGRAPHIE
[1] Olivier Dequincey, 17/11/2022. Le sol, les sols, Planet Terre - ISSN 2552-9250, https://planet-terre.ens-lyon.fr/ressource/FEL2022.xml
[2] Adal, Y. M. The Impact of Beneficial Microorganisms on Soil Vitality: A Review. Front. Environ. Microbiol. 2024, 10(2), 45-53. https://doi.org/10.11648/j.fem.20241002.12
[3] United States Environmental Protection Agency (EPA). What is Acid Rain? (2023) https://www.epa.gov/acidrain/what-acid-rain
[4] Smithsonian Magazine. (2013, October 14). Acid Rain and Our Ecosystem (2013). https://www.smithsonianmag.com/science-nature/acid-rain-and-our-ecosystem-20824120/
[5] Air parif. Dossier mai 2025. n10.
https://www.airparif.fr/sites/default/files/document_publication/biodiv_16pages_web.pdf
[6] European Environment Agency (EEA). (2025). Emissions of the main air pollutants in Europe. Consulté le 23 octobre 2025. https://www.eea.europa.eu/en/analysis/indicators/emissions-of-the-main-air
[7] Sterckeman, T., Douay, F., Proix, N., Fourrier, H., Perdrix, E., & Ciesielski, H. (2000). Contamination of urban soils in an area of northern France polluted by dust emissions of two smelters. Water, Air, and Soil Pollution, 118(1–2), 229–248. https://doi.org/10.1023/A:1005191209477
[8] Gill, A. S., et al. (2020). Microbial Composition and Functional Diversity Differ Across Urban Land-Use. Microbiole frontale. 5 juin 2020;11:912. DOI : 10.3389/fmicb.2020.00912.
[9] Lu Z., et al. (2018) . Isolation, identification and characterization of novel Bacillus subtilis. The Journal of veterinary medical science, 80(3), 427–433. https://doi.org/10.1292/jvms.16-0572
[10] DeBritto, S., Gajbar, T.D., Satapute, P. et al. Isolation and characterization of nutrient dependent pyocyanin from Pseudomonas aeruginosa and its dye and agrochemical properties. Sci Rep 10, 1542 (2020). https://doi.org/10.1038/s41598-020-58335-6
[11] 6-3 Streptomyces. Virtual microbiology. Streptomyces
[12] American Society for Microbiology. Power point colony-morphology.pptx
Image Gallery. Colony Morphology. Sept. 1, 2007 Colony Morphology
[13] Prakash, O., Nimonkar, Y., Shaligram, S. et al. Response of cellular fatty acids to environmental stresses in endophytic Micrococcus spp.. Ann Microbiol 65, 2209–2218 (2015). https://doi.org/10.1007/s13213-015-1061-x
[14] Wilks, J. C., & al. (2009). Acid and base stress and transcriptomic responses in Bacillus subtilis. Applied and environmental microbiology, 75(4), 981–990. https://doi.org/10.1128/AEM.01652-08
[15] Effects of Simulated Acid Rain on Soil Enzyme Activity and Related Chemical Indexes in Woodlands. https://www.mdpi.com/1999-4907/13/6/860?

No Comments